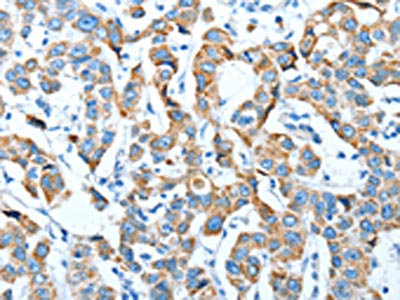

TNNI3 Antibody
-
中文名稱:TNNI3兔多克隆抗體
-
貨號:CSB-PA119248
-
規格:¥1100
-
圖片:
-
The image on the left is immunohistochemistry of paraffin-embedded Human thyroid cancer tissue using CSB-PA119248(TNNI3 Antibody) at dilution 1/20, on the right is treated with fusion protein. (Original magnification: ×200)
-
The image on the left is immunohistochemistry of paraffin-embedded Human breast cancer tissue using CSB-PA119248(TNNI3 Antibody) at dilution 1/20, on the right is treated with fusion protein. (Original magnification: ×200)
-
Gel: 12%SDS-PAGE, Lysate: 40 μg, Lane: Mouse heart tissue, Primary antibody: CSB-PA119248(TNNI3 Antibody) at dilution 1/200, Secondary antibody: Goat anti rabbit IgG at 1/8000 dilution, Exposure time: 10 seconds
-
-
其他:
產品詳情
-
Uniprot No.:
-
基因名:
-
別名:cardiac muscle antibody; Cardiac troponin I antibody; cardiomyopathy; dilated 2A (autosomal recessive) antibody; Cardiomyopathy; familial hypertrophic; 7; included antibody; CMD1FF antibody; CMD2A antibody; CMH7 antibody; cTnI antibody; Familial hypertrophic cardiomyopathy 7 antibody; MGC116817 antibody; RCM1 antibody; Tn1 antibody; Tni antibody; TNN I3 antibody; TNNC 1 antibody; TNNC1 antibody; TNNI3 antibody; TNNI3_HUMAN antibody; Troponin I antibody; Troponin I cardiac antibody; Troponin I cardiac muscle antibody; Troponin I cardiac muscle isoform antibody; Troponin I type 3 cardiac antibody; troponin I; cardiac 3 antibody; TroponinI antibody; Ttroponin I type 3 (cardiac) antibody
-
宿主:Rabbit
-
反應種屬:Human,Mouse,Rat
-
免疫原:Fusion protein of Human TNNI3
-
免疫原種屬:Homo sapiens (Human)
-
標記方式:Non-conjugated
-
抗體亞型:IgG
-
純化方式:Antigen affinity purification
-
濃度:It differs from different batches. Please contact us to confirm it.
-
保存緩沖液:-20°C, pH7.4 PBS, 0.05% NaN3, 40% Glycerol
-
產品提供形式:Liquid
-
應用范圍:ELISA,WB,IHC
-
推薦稀釋比:
Application Recommended Dilution ELISA 1:2000-1:5000 WB 1:200-1:1000 IHC 1:25-1:100 -
Protocols:
-
儲存條件:Upon receipt, store at -20°C or -80°C. Avoid repeated freeze.
-
貨期:Basically, we can dispatch the products out in 1-3 working days after receiving your orders. Delivery time maybe differs from different purchasing way or location, please kindly consult your local distributors for specific delivery time.
-
用途:For Research Use Only. Not for use in diagnostic or therapeutic procedures.
相關產品
靶點詳情
-
功能:Troponin I is the inhibitory subunit of troponin, the thin filament regulatory complex which confers calcium-sensitivity to striated muscle actomyosin ATPase activity.
-
基因功能參考文獻:
- Data show that the incident atrial fibrillation (AF) occurrence group had similar baseline troponin I (TnI) levels, but higher troponin T (TnT) levels [Review and Meta-Analysis]. PMID: 29631448
- Studies indicate that in patients with end-stage renal disease (ESRD), elevation of cardiac-specific troponin T (cTnT) was more frequent than elevation of troponin I (cTnI) [Review]. PMID: 28545334
- the frequency of h-FABP positivity among acute myocardial infarction patients was higher than that of hs-TnI, which would have missed six of them; however, hs-TnI area under curve was superior to that of h-FABP. PMID: 28650717
- Reversible Covalent Reaction of Levosimendan with Cardiac Troponin C in Vitro and in Situ. PMID: 29558109
- The QT interval has a strong positive linear correlation with cardiac troponin-I levels in Non-ST-elevation myocardial infarction. PMID: 28366473
- Apelin-12 influences troponin I levels in the acute phase of STEMI, whereas during the non-acute phase, low apelin levels were associated with a high rate of MACE. PMID: 28728608
- In clinical stable patients without known cardiovascular disease, a thorough chest-pain history in combination with hs-TnI testing can identify a significant low-risk group. PMID: 28031149
- Study showed that in patients who underwent liver transplantation elevation of preoperative high-sensitivity cardiac troponin I level was associated with 1-year mortality and 30-day mortality. PMID: 28542299
- Serial measurement of troponin I revealed a persistent elevation in patients with diabetes mellitus type 2. PMID: 28246236
- Plasma troponin C1 (cTnI) is biomarker of choice for diagnosing acute myocardial infarction (AMI) because of its high specificity as biomarker for damage to myocardial tissue. Data suggest the "best cut-off" for plasma cTnI is 0.014 micrograms/L in AMI. These studies were conducted in emergency department of a university hospital in Italy using point-of-care testing in patients presenting with chest pain, ages 18-101. PMID: 28377153
- NT-proBNP and hs-cTnI levels were higher in systemic sclerosis patients than controls. Both NT-proBNP and hs-cTnI were associated with the presence of echocardiographic abnormalities. PMID: 27601074
- value of cTnI level assessed 24 hours post-surgery was a reliable predictor of death following liver transplantation with optimal cut-off value of 0.215 ng/mL. The surgery time was the most important predictor of cTnI elevation. PMID: 28455997
- cTnI levels are common in Fabry disease patients, reflecting cardiac involvement. PMID: 27322070
- Report novel troponin I rule-out value below the upper reference limit for acute myocardial infarction. PMID: 27067356
- cTnI determined in hemodynamically stable patients with suspected AMI and wide QRS complex using optimized diagnostic thresholds improves rule-in and rule-out with respect to presence of a significant obstructive CAD PMID: 27148734
- 83 preterm infants with Bronchopulmonary dysplasia born <28-wk gestation and still inpatients at 36-wk corrected age received an echocardiogram and blood tests of B-type natriuretic peptide (BNP), troponin I, and YKL-40. PMID: 27760764
- Serum cardiac troponin I was increased in septic patients with myocardial depression compared to those without myocardial depression. PMID: 27238916
- Elevated BNP and hs-cTnI after kidney transplantation identify candidates for targeted risk reduction. PMID: 26910333
- These perturbed biophysical and biochemical myofilament properties are likely to significantly contribute to the diastolic cardiac pump dysfunction that is seen in patients suffering from a restrictive cardiomyopathy that is associated with the cTnI R145W mutation. PMID: 27557662
- epigenetic modification caused cTnI expression decrease is one of the possible causes that result in a reduced cTnI level and diastolic dysfunction in older mouse hearts PMID: 27184165
- Among hospitalized patients with cardiac troponin I values above 30 ng/L, the majority will have myocardial injury. Cardiac nonischemic conditions are associated with very high troponin concentrations, but the outcome is rather good. In contrast, myocardial injury related to noncardiac or multiple conditions carries a very poor long-term prognosis. PMID: 26763756
- troponin I carboxy terminal mobile domain and linker sequence has a role in regulating cardiac contraction PMID: 26971468
- the last 5 C-terminal residues of cTnI influence the binding of cTnI with cTnC and cTnT and affect the Ca(2+) dependence of filament sliding PMID: 26919894
- Study found that N-terminal pro-brain natriuretic peptide (NT-proBNP) and high-sensitivity cardiac troponin I are independently associated with incident dementia and NT-proBNP with incident Alzheimer's disease PMID: 28039523
- The clones were selected using microtiter plate coated with human cardiac troponin I (hcTnI). Product of hybridoma cells that bind with high affinity to human cardiac troponin I were selected PMID: 27556913
- Sex, age, and systolic blood pressure belong to the strongest determinants of hs-cTnI in healthy adults. PMID: 27535138
- This review summarizes the recent proteomic data on aminoacid sequences of cTnT and cTnI in various species, as well as selected analytical characteristics of human cardiac troponin high-sensitivity assays PMID: 26876101
- In stable coronary artery disease patients successfully treated with PCI, pre-procedural cTnI levels, in the upper limits of the normal range, are associated with hard cardiac endpoints. PMID: 25405803
- Calcium channel blockers and adrenergic beta antagonists reduced hs-TnI levels significantly both at rest and during exercise in atrial fibrillation patients/. PMID: 27142292
- Compromised interactions of K206I with actin and hcTnC may lead to impaired relaxation and HCM. PMID: 26553696
- hsTnI at the time of presentation followed by early advanced coronary CTA assessment improves the risk stratification and diagnostic accuracy for acute coronary syndromes. PMID: 26476506
- These findings showed that a double heterozygous mutation in the TNNI3 gene is involved in the pathogenesis of hypertrophic cardiomyopathy via haploinsufficiency. PMID: 26506446
- The incidence of adverse cardiovascular events was significantly higher in patients with troponin elevation after carotid endarterectomy, which was mainly attributable to silent non-ST segment elevation MIs that occurred in the early post-operative phase. PMID: 26553374
- Four novel missense variants were identified in TNNI3. PMID: 26169204
- Letter/Case Report: acute decompensated heart failure with troponin I elevation in hereditary hemochromatosis. PMID: 25916738
- In this pilot study, the addition of CACS to hsTnI improves the identification of low-risk subjects in whom CTA might be avoided. PMID: 26049777
- Exclusion of acute myocardial infarction 2h after presentation in emergency patients with possible acute coronary syndrome can be achieved using hs-cTnT or hs-cTnI assays. PMID: 24316100
- Hybrid coronary revascularization is associated with lower postoperative cTn release, compared with off-pump coronary artery bypass surgery. PMID: 25217621
- Carotid endarterectomy is followed by a high incidence of asymptomatic cTnI increase that is associated with late cardiac events. PMID: 25601178
- mutations underlying restrictive cardiomyopathy all marked by right-sided cardiac manifestations in South African patients PMID: 25940119
- Circulating levels of sensitive cTnI and NT-proBNP are related to LV function and infarct size in patients with stable CAD after revascularization. PMID: 25788439
- Serum TnI detected significant myocardial necrosis in a majority of patients with chronic HF due to LVSD and when measured serially, provided independent risk information for poor CV outcomes and deleterious LV remodeling. PMID: 25777344
- The elevation of Tn I after PCI in patients with normal initial level is more significant predictor of early (30-day) mortality compared to later (within 12 months) mortality. PMID: 25617100
- AF patients both without and with CAD showed similar cTnI concentrations at admission. A second validation of cTnI is mandatory for all patients. PMID: 25653186
- cardiac troponin T or troponin I compared to creatine kinase in patients with revascularized acute myocardial infarction PMID: 25381953
- Even a single elevated Troponin I value increased the risk of myocardial infarction. PMID: 25195101
- Abbott high-sensitivity cardiac-TnI levels in a total of 3314 Korean patients with chest pain, were determined. PMID: 25887868
- Absolute delta performed significantly better than relative delta at all time intervals to measure changes in troponin I for early diagnosis of myocardial infarction. PMID: 25261587
- The high accordance with LGE, reflecting cardiac dysfunction, suggests that cTNI-elevation can be a useful laboratory parameter for assessing myocardial damage in FD. PMID: 24626231
- Using an overall 99th percentile for cTnI does not appear to increase the prevalence of myocardial injury or lead to further hospital admissions from the emergency department. PMID: 26185217
顯示更多
收起更多
-
相關疾病:Cardiomyopathy, familial hypertrophic 7 (CMH7); Cardiomyopathy, familial restrictive 1 (RCM1); Cardiomyopathy, dilated 2A (CMD2A); Cardiomyopathy, dilated 1FF (CMD1FF)
-
蛋白家族:Troponin I family
-
數據庫鏈接:
Most popular with customers
-
-
YWHAB Recombinant Monoclonal Antibody
Applications: ELISA, WB, IHC, IF, FC
Species Reactivity: Human, Mouse, Rat
-
-
-
-
-
-